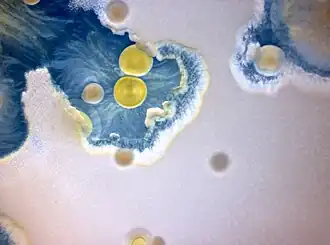

Myxococcus
| Myxococcus | |||||||||||
|---|---|---|---|---|---|---|---|---|---|---|---|
| |||||||||||
| Ontwikkelende kolonie van M. xanthus (geel) | |||||||||||
| Taxonomische indeling | |||||||||||
| |||||||||||
| Geslacht | |||||||||||
| Myxococcus Thaxter 1892 | |||||||||||
| Myxococcus op | |||||||||||
| |||||||||||
Myxococcus is een geslacht van sporenvormende bacteriën in de familie Myxococcaceae. Myxococci zijn gramnegatieve, obligaat aerobe bacteriën. De cellen komen voor als langwerpige staafjes met afgeronde uiteinden. De bacteriën komen voor in bodems. Er zijn ten minste elf soorten beschreven. De best gekarakteriseerde soort is Myxococcus xanthus.
De cellen van Myxococcus-bacteriën kennen vergaande samenwerking en sociale interacties tijdens hun kolonievorming. Ze kunnen verschillende multicellulaire structuren vormen. De cellen bewegen in een groeiende kolonie door te 'kruipen' en kunnen daarbij andere bacteriën opnemen, een soort vorm van georganiseerde predatie. Communicatie vindt plaats door onder meer quorum sensing.[1]
Een opvallend kenmerk van Myxococcus is de vorming van vruchtlichamen ('fruiting bodies'), bestaande uit ongeveer 50.000 cellen. De bacteriën vormen deze vruchtlichamen als reactie op chemische signalen door stressfactoren, bijvoorbeeld voedselgebrek. De vruchtlichaampjes stellen de bacteriën vervolgens in staat om te transformeren in ronde sporen die bestand zijn tegen de omgeving. Er is relatief veel onderzoek verricht naar de mechanismen van cel-celcommunicatie en de signaalsystemen in Myxococcus-bacteriën.[2]
Bronnen
- ↑ (en) Cao, P., Dey, A., Vassallo, CN., Wall, D. (2015). How Myxobacteria Cooperate. Journal of Molecular Biology 427 (23): 3709–3721. PMID 26254571. PMC 4658263. DOI: 10.1016/j.jmb.2015.07.022.
- ↑ (en) Curtis, PD., Taylor, RG., Welch, RD., Shimkets, LJ. (2007). Spatial organization of Myxococcus xanthus during fruiting body formation. Journal of Bacteriology 189 (24): 9126–9130. PMID 17921303. PMC 2168639. DOI: 10.1128/JB.01008-07.